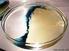
Versuch 8 Konzentrations- und Temperaturabhängigkeit der Zersetzungsspannung

Systemdynamik: Iodwasserstoff-Gleichgewicht
|
|
|
- Michaela Becke
- vor 7 Jahren
- Abrufe
Transkript
1 1 Systemdynamik: Iodwasserstoff-Gleichgewicht Inhalt 1 Einleitung Reaktionsgleichung, Substanzdaten Simulation Simulationsdiagramm (Reaktions Typ 3) Zeitdiagramme Dokumentation (Gleichungen und Parameter) Vergleich von Messung und Simulation Folgerung: Literatur Einleitung Schon 1767 hat Pierre Joseph Macquer festgestellt, dass einige chemische Reaktionen nicht nur in eine Richtung laufen 1. Das Iodwasserstoff-Gleichgewicht zieht sich durch die Lehrbücher der Chemie 2,3,4,5 und die chemische Literatur 6,7,8,9,10 seit Ende des vorletzten und Beginn des letzten Jahrhunderts genau ausgemessen wurde 1894 es von einem Begründer der chemischen Kinetik, Max Bodenstein 11. Dieses Beispiel wurde wohl deshalb so früh und eingehend beschrieben, weil es mit den damaligen experimentellen Möglichkeiten gut zugänglich war. Wasserstoff (H 2 ) lässt sich volumetrisch erfassen, Iod (I 2 ) kann mit einer Redox-Reaktion titriert werden und Iodwasserstoff (HI) 12 in Wasser leicht absorbiert und kann so mit einer Säure-Titration quantitativ bestimmt werden. Auch die Drücke ändern sich bei dieser Absorption praktisch quantitativ. Selbst die Katalyse dieser Reaktion lässt sich bis in diese Zeit zurückverfolgen. Dieses gute Beispiel einer Gleichgewichts-Einstellung hat keine praktische Anwendung gefunden. Walter Nernst hat das Iodwasserstoff-Gleichgewicht unter dem Kapitel Chemische Statik beschrieben 13, und wird den Eindruck nicht los, dass man bis heute noch nicht gemerkt hat, dass chemische Gleichgewichte dynamische Gleichgewichte sind. Noch immer werden in Chemie-Lehrbüchern Gleichgewichte behandelt, ohne auf die Reaktionsgeschwindigkeiten einzugehen. Auch der legendäre Linus Pauling verwendet das Beispiel, aber mit einer falschen Temperatur oder einer falschen Gleichgewichtskonstanten 14. Aber solche Fehler werden noch immer kaum beachtet. Hans-Georg Winkler schreibt im Vorwort zum Buch Das Massenwirkungsgesetz 15 : Inzwischen hat sich (wie übrigens auch in der Mathematik) in der Schulchemie ein Wandel vollzogen, den man als Übergang von einer statischen zu einer kinetisch-funktionalen Denkweise charakterisieren könnte. Man versuchte von der sehr stark auf Stoffbeschreibungen und auf die Ableitung starrer Modelle ausgerichteten Chemie wegzukommen und die chemische Reaktion selbst in den Mittelpunkt zu stellen. Leider ist es bis bei diesen Versuchen geblieben. Mit der Systemdynamik ist heute eine jedoch perfekte, wissenschaftlich korrekte Methodik vorhanden dynamische chemische Prozesse zu modellieren, simulieren und mit den Messungen zu vergleichen 16 - die Lösungen der mathematischen Gleichungen werden bei der Simulation mit numerischen Verfahren gefunden. Man kann sich somit auf die chemischen und nicht auf die mathematischen Probleme konzentrieren das machen selbst die Mathematiker mit Mathematiksoftware.
2 2 2 Reaktionsgleichung, Substanzdaten Hinreaktion: H 2 (g) + I 2 (g) 2 HI (g) ΔH 0 = -11 [kj/mol], exotherme Reaktion 17 Aktivierungsenergie ΔG = +22 [kj/mol]; Tabelle 1: Thermodynamik 18,19 Substanz Elektronenhülle ΔH 0 f [kj/mol] ΔS 0 [J/mol/K] ΔG 0 f [kj/mol] Dichteverteilung H 2 (g) I 2 (g) HI (g) Reaktion Iodwasserstoff, HI, bildet mit Wasser die sehr starke Iodwasserstoff-Säure. Es ist eine ausserordentlich starke Säure: pks(hi)= ca. -10 Gleichung der Gleichgewichtsreaktion: H 2 (g) + I 2 (g) 2 HI (g) Die Vorwärtsreaktion und die Rückwärtsreaktion, beide sind je von 2 reagierenden Teilchen abhängig. Somit handelt es sich um Reaktionen 2. Ordnung 20. Tabelle 2: Substanzdaten Substanz R-Sätze S-Sätze Iod R: 20/21-50 S: (2-) Wasserstoff R: 12 S: (2-) Iodwasserstoff R: 35 S: (1/2-) /37/39-45 Gefahrensymbole Xn F+ C N Meist wird bei der Diskussion dieser Reaktion kein Experiment gezeigt, ein gutes Video zum Gleichgewicht kann diese Situation verbessern:
3 3 3 Simulation Annahmen: Das Modell geht von der einfachen Dissoziation von HI und der Reaktion von H 2 mit I 2 ohne Zwischenstufen aus (obwohl sich aus I 2 zuerst 2 I bilden). Mit dem Modell soll versucht werden, die vorhandenen experimentellen Daten nachzubilden. Die Gleichgewichtskonstante für 712 K ist aus den Literaturdaten (Tabelle 3) extrapoliert K=22. Statt mit Mengen, wird mit Prozenten gerechnet (zum Vergleich mit dem Experiment). Die Geschwindigkeitskonstanten werden mit der Simulation ermittelt und dann mit Messwerten verglichen. 3.1 Simulationsdiagramm (Reaktions Typ 3 21 ) H2 k hin K I2 k rück RG1 RG2 2 HI K ber Abbildung 1: Simulationsdiagramm der Reaktion H 2 + I 2 2 HI (das Simulations-Modell) Wichtig: Die Reaktionsgeschwindigkeit RG1 von Wasserstoff ist gleich gross wie RG2 von Iod. 3.2 Zeitdiagramme Vergleich mit Messung Gleichgewichtseinstellung Prozent Prozent Time (Minute) "2 HI" : Current Time (Minute) "2 HI" : Current Abbildung 2: Zeitdiagramm: Abbildung 3: Zeitdiagramm: Gleichgewichtseinstellung der ersten 90 Minuten Gleichgewichtseinstellung der ersten 600 Minuten. Erst nach ca. 150 Minuten ist die Gleichgewichtskonstante einigermassen konstant.
4 4 3.3 Dokumentation (Gleichungen und Parameter) (01) "2 HI"= INTEG (RG1+RG2, 0) Units: Prozent [0,?] (02) FINAL TIME = 600 Units: Minute The final time for the simulation. (03) H2= INTEG (-RG1, 50) Units: Prozent [0,?] Wasserstoffgas, bei einem Gas entsprechen die Volumenteile in Prozent auch den Anteilen in Mol (04) I2= INTEG (-RG2, 50) Units: Prozent [0,?] Iodgas, bei einem Gas entsprechen die Volumenteile in Prozent auch den Anteilen in Mol (05) INITIAL TIME = 0 Units: Minute The initial time for the simulation. (06) K= 25 Units: Dmnl [0,16000] Gleichgewichts-Konstante (07) K ber= 0.5*"2 HI"*0.5*"2 HI"/(I2*H2) Units: Dmnl [0,?] HI entspricht 0.5* 2 HI (08) k hin= Units: 1/(Minute*Prozent) [0,0.01] Reaktionsgeschwindigkeits-Konstante (09) k rück= k hin/k Units: 1/(Minute*Prozent) [0,?] Reaktionsgeschwindigkeits-Konstante (10) RG1= k hin*h2*i2-k rück*(0.5*"2 HI")*(0.5*"2 HI") Units: Prozent/Minute [0,?] Reaktionsgeschwindigkeit, Gleichzeitig wird I2 und H2 gebildet, also braucht es für ein I2 und ein H2 nur zwei HI (11) RG2= RG1 Units: Prozent/Minute [0,?] Reaktionsgeschwindigkeit,, Diese Reaktionsgeschwindigkeit entspricht genau der von Wasserstoff zu HI (12) SAVEPER = 1 Units: Minute [0,?] The frequency with which output is stored. (13) TIME STEP = 0.1 Units: Minute [0,?] The time step for the simulation.
5 5 3.4 Vergleich von Messung und Simulation Anteil (%) HI-Bildung HI-Zerfall Simulation Zeit (Minuten) Abbildung 4: Vergleich von Messung und Simulation (Temperatur: 721 K) Die Halbwertszeit dieser Reaktion 2. Ordnung 22 kann aus der Reaktionsgeschwindigkeits- Konstante berechnet werden mit der Formel: HWZ = k hin 1 I (%) 2 = 1 = Dieser Wert stimmt mit den Messungen recht gut überein. Tabelle 3: Vergleich mit Literaturdaten Temperatur Temperatur [ C] [K] Gleichgewichtskonstante K 23,24 K (Simulation) Basis: Temperatur 721 [K] K 22 ( ΔG /(R T)) K = e ; Gleichgewichtskonstante (ΔG aus Tabelle 1); K (298 K) = 99 Hier ist noch eine recht grosse Diskrepanz zu den gemessenen K-Werten vorhanden! Mit der Gleichung von Arrhenius ergibt sich für die Umrechnung der Gleichgewichtskonstanten für eine bestimmte Temperatur 27 : K 2 ΔH T2 T1 log = ; die Überprüfung der Messwerte von 298 und 700 K mit dieser K R T2 T1 Formel ergab eine Übereinstimmung mit 10% Abweichung.
6 6 Tabelle 4: Reaktionsgeschwindigkeits-Konstante der Bildung von HI 28 Temperatur [K] k [M/s] x x x 10-2 Interpolation: Temperatur 721 K k 0.007; Modellwert: k hin= ; Die Abweichung zwischen diesem Literaturwert und dem Modellwert ist mit dem Faktor 4.7 beachtlich. Bei den experimentellen Daten fehlen jedoch die wichtigen Hinweise über den Druck und die Konzentrationen resp. Mengen. 3.5 Folgerung: Das Gleichgewicht H 2 (g) + I 2 (g) 2 HI(g) stellt sich bei über 400 C erst nach mehr als 2 Stunden ein. Daher ist es sehr verwunderlich, dass dieser Ablauf in den Lehrbüchern, Aufgabensammlungen und Skripts der Chemie so weit verbreiteten Gleichgewichts mit der Reaktionsgeschwindigkeit kaum in Verbindung gebracht und mit guten Daten so wenig gestützt ist. Für die praktische Umsetzung von Reaktionen ist die Dynamik wichtig. Satisfaction of one's curiosity is one of the greatest sources of happiness in life. Linus Carl Pauling ( ), amerikanischer Chemiker Dynamik kann viel Motivation bringen, denn hier werden die Fragen nach der Reaktivität gestellt. Mit dem nicht präzise definierten Begriff Reaktivität bezeichnet man in der Chemie die Eigenschaft von Atomen und Molekülen, eine chemische Reaktion einzugehen. Substanzen, die für die Reaktion nur eine geringe Aktivierungsenergie benötigen, werden als sehr reaktiv bezeichnet, solche mit einer hohen Aktivierungsenergie als inert. Die Reaktionsgeschwindigkeitskonstante ist ein Mass für die Reaktivität in unserem Fall von H 2 /I 2 und HI ist diese Reaktivität relativ klein. Der Bau der Moleküle kann hier einige gute Antworten geben. 4 Literatur 1 Herrn Peter Joseph Macquers, Chymisches Wörterbuch oder Allgemeine Begriffe der Chymie nach alphabetischer Ordnung, Weidmannische Buchhandlung, Leipzig, Naumann Alexander Nicolaus Franz, Lehr- und Handbuch der Thermochemie, F. Vieweg, 1882, S Kolbe Hermann, Winkelmann Adolph August, Landolt Hans, Michaelis August, Horstmann August Friedrich, Graham Thomas, Graham-Otto's ausführliches Lehrbuch der Chemie, F. Vieweg und Sohn, 1885, S Feitknecht Walter, Grundriss der Allgemeinen und Physikalischen Chemie, Ernst Reinhardt Verlag A.G., Basel, 1949, S Dickerson Richard E., Geis Irving, Chemie, Verlag Chemie, Weinheim, 1981, p Hautefeuille Paul, Compt. Rend., 64, 1867, p. 618, Lemoine Clément Georges, Ann. Chim. Phys., [5] 12, 1877, p. 145 zitiert in: Nernst Walter, Theoretische Chemie, Achte- Zehnte Auflage, Ferdinand Enke, Stuttgart, 1921, S Hoff Jacobus Henricus, Vorlesungen über theoretische und physikalische Chemie, F. Vieweg und Sohn, 1898, S Bodenstein Max Ernst August, Einfl. D. Temperatur auf Bildg. U. Zers. Von Jodwasserstoff, Deutsche Chemische Gesellschaft, Verein Deutscher Chemiker, L. Voss, 1899:2, S.331
7 7 9 Höber Rudolf, Physikalische Chemie der Zelle und der Gewebe, W. Engelmann, 1902, S. 77, 278, Nernst Walther, Theoretische Chemie, F. Enke, 1903, S. 278, Bodenstein Max Ernst August, Z. phys. Chem., 13, 1894, S Jodwasserstoff, Meyers Konversationslexikon, Autorenkollektiv, Verlag des Bibliographischen Instituts, Leipzig und Wien, , Vierte Auflage, S Nernst Walter, Theoretische Chemie, Achte-Zehnte Auflage, Ferdinand Enke, Stuttgart, 1921, S Pauling Linus, Chemie, eine Einführung, Verlag Chemie, Weinheim, 1962, S Winkler Hans-Georg, Das Massenwirkungsgesetz, Aulis-Verlag Deubner, Köln, 2.Aufl., 1975, S Bützer Peter, Roth Markus, Die Zeit im Griff, verlag pestalozzianum, Zürich Flörke Wilhelm, Wolff Robert, Glaum Erwin, Kursthemen Chemie, Allgemeine und Physikalische Chemie, Bildungsverlag EINS GmbH, Troisdorf, CRC Handbook of Chemistry and Physics, CRC Press, Boca Raton, 1980, 61 st Edition, D Aylward Gordon H., Datensammlung Chemie in SI-Einheiten, Verlag Chemie GmbH, Weinheim, 1975, S Stevens B., Chemical Kinetics, Chapman & Hall, London 1961, p Bützer Peter, Roth Markus, Die Zeit im Griff, verlag pestalozzianum, Zürich 2006, S. 50ff 22 Winkler Hans-Georg, Das Massenwirkungsgesetz, Aulis-Verlag Deubner, Köln, 2.Aufl., 1975, 59ff 23 Atkins Peter, Jones Loretta, Chemical Principles, W.H. Freeman and Company, New York, 1998, p Mortimer Charles E., Chemie, Georg Thieme Verlag, Stuttgart, 1973, S Winkler Hans-Georg, Das Massenwirkungsgesetz, Aulis-Verlag Deubner, Köln, 2.Aufl., 1975, S Dickerson Richard E., Geis Irving, Chemie, Verlag Chemie, Weinheim, 1981, p Atkins Peter, Jones Loretta, Chemical Principles, W.H. Freeman and Company, New York, 1998, p Purdue University, Chemistry, Activation Energy,
Die Geschwindigkeit zum Gleichgewicht
 2F 3F 6F 7F 8F Inhalt Die Geschwindigkeit zum Gleichgewicht Peter Bützer 0H1 1H2 2H3 8H4 15H5 Einleitung... 17H1 Reaktionsgleichung, Substanzdaten... 18H2 Simulation... 19H3 3H3.1 Simulationsdiagramm (Reaktions-Typ
2F 3F 6F 7F 8F Inhalt Die Geschwindigkeit zum Gleichgewicht Peter Bützer 0H1 1H2 2H3 8H4 15H5 Einleitung... 17H1 Reaktionsgleichung, Substanzdaten... 18H2 Simulation... 19H3 3H3.1 Simulationsdiagramm (Reaktions-Typ
Kohlenmonoxid aus Ethanal, CH 3 -CHO
 Kohlenmonoxid aus Ethanal, CH 3 -CHO Peter Bützer Chemiker haben viele nette Reaktionen! Inhalt 1 Einleitung/Theorie... 1 2 Aufgabenstellung... 2 2.1 Beobachtungen/Messungen, Datenbasis... 2 2.2 Reaktionsgleichungen/Berechnungen...
Kohlenmonoxid aus Ethanal, CH 3 -CHO Peter Bützer Chemiker haben viele nette Reaktionen! Inhalt 1 Einleitung/Theorie... 1 2 Aufgabenstellung... 2 2.1 Beobachtungen/Messungen, Datenbasis... 2 2.2 Reaktionsgleichungen/Berechnungen...
Michaelis-Menten-Kinetik
 Michaelis-Menten-Kinetik Peter Bützer Inhalt 1 Einführung... 1 2 Modell... 2 2.1 Modellannahmen... 2 2.2 Drei Fälle... 2. Simulationsdiagramm (Typ ), Systemdynamik... 2.4 Dokumentation (Gleichungen, Parameter)...
Michaelis-Menten-Kinetik Peter Bützer Inhalt 1 Einführung... 1 2 Modell... 2 2.1 Modellannahmen... 2 2.2 Drei Fälle... 2. Simulationsdiagramm (Typ ), Systemdynamik... 2.4 Dokumentation (Gleichungen, Parameter)...
Kohlendioxidfreisetzung aus Champagner. 1 Einleitung/Theorie. Peter Bützer. Inhalt
 Kohlendioxidfreisetzung aus Champagner Inhalt 1 Einleitung/Theorie... 1 2 Experiment... 2 2.1 Aufgabenstellung... 2 2.2 Durchführung... 2 2.3 Beobachtungen/Messungen... 2 2.4 Reaktionsgleichungen/Berechnungen...
Kohlendioxidfreisetzung aus Champagner Inhalt 1 Einleitung/Theorie... 1 2 Experiment... 2 2.1 Aufgabenstellung... 2 2.2 Durchführung... 2 2.3 Beobachtungen/Messungen... 2 2.4 Reaktionsgleichungen/Berechnungen...
2 NO 2 N 2 O 4, ein einfaches Gleichgewicht
 2 NO 2 N 2 O 4, ein einfaches Gleichgewicht Peter Bützer Inhalt 1 Einführung... 1 2 Grundlagen zur Reaktion... 1 3 Simulation (Typ 3), Systemdynamik... 4 3.1 Das einfache Gleichgewicht... 4 3.2 Das Prinzip
2 NO 2 N 2 O 4, ein einfaches Gleichgewicht Peter Bützer Inhalt 1 Einführung... 1 2 Grundlagen zur Reaktion... 1 3 Simulation (Typ 3), Systemdynamik... 4 3.1 Das einfache Gleichgewicht... 4 3.2 Das Prinzip
Ethanolbildung in Bananen
 Ethanolbildung in Bananen Peter Bützer Inhalt 1 Einführung... 1 2 Modell... 2 2.1 Annahmen:... 2 2.2 Simulation(Typ 1)... 2 2.3 Dokumentation (Gleichungen, Parameter)... 3 2.4 Vergleich der Simulation
Ethanolbildung in Bananen Peter Bützer Inhalt 1 Einführung... 1 2 Modell... 2 2.1 Annahmen:... 2 2.2 Simulation(Typ 1)... 2 2.3 Dokumentation (Gleichungen, Parameter)... 3 2.4 Vergleich der Simulation
Titration einer Säure mit einer Base
 Titration einer Säure mit einer Base Peter Bützer Inhalt 1 Einleitung... 1 2 Modellannahmen (Systemdynamik)... 2 3 Simulationsdiagramm (Typ 1)... 2 4 Dokumentation (Gleichungen, Parameter)... 3 5 Simulation...
Titration einer Säure mit einer Base Peter Bützer Inhalt 1 Einleitung... 1 2 Modellannahmen (Systemdynamik)... 2 3 Simulationsdiagramm (Typ 1)... 2 4 Dokumentation (Gleichungen, Parameter)... 3 5 Simulation...
Phototrope Gläser. Dr. Peter Bützer. Inhalt
 1 Phototrope Gläser Inhalt 1 Einleitung/Theorie... 2 2 Experiment... 2 2.1 Aufgabenstellung... 2 2.2 Durchführung... 2 2.3 Beobachtungen/Messungen... 3 2.4 Reaktionsgleichungen/Berechnungen... 3 3 Simulation,
1 Phototrope Gläser Inhalt 1 Einleitung/Theorie... 2 2 Experiment... 2 2.1 Aufgabenstellung... 2 2.2 Durchführung... 2 2.3 Beobachtungen/Messungen... 3 2.4 Reaktionsgleichungen/Berechnungen... 3 3 Simulation,
Gipshärtung Energiefreisetzung, Systemdynamik
 Gipshärtung Energiefreisetzung, Systemdynamik Inhalt 1 Reaktion... 1 2 Experiment... 2 3 Simulation... 3 3.1 Simulationsdiagramm... 3 3.2 Dokumentation (Gleichungen, Parameter)... 3 3.3 Zeitdiagramm...
Gipshärtung Energiefreisetzung, Systemdynamik Inhalt 1 Reaktion... 1 2 Experiment... 2 3 Simulation... 3 3.1 Simulationsdiagramm... 3 3.2 Dokumentation (Gleichungen, Parameter)... 3 3.3 Zeitdiagramm...
Atmung, Dissimilation
 Atmung, Dissimilation Peter Bützer Abbildung 1: Atmung Inhalt 1 Physiologisches... 1 2 Atmung, eine Reaktion 0. Ordnung... 2 3 Simulation... 2 4 Interpretation... 4 5 Mikroökologie im Zimmer... 4 6 Interpretation...
Atmung, Dissimilation Peter Bützer Abbildung 1: Atmung Inhalt 1 Physiologisches... 1 2 Atmung, eine Reaktion 0. Ordnung... 2 3 Simulation... 2 4 Interpretation... 4 5 Mikroökologie im Zimmer... 4 6 Interpretation...
Daisyworld. Peter Bützer. 1 Eine kurze Theorie. Inhalt
 Daisyworld Peter Bützer Inhalt 1 Eine kurze Theorie... 1 2 Aufgabe... 2 3 Simulation, Lösung (Typ 3), Systemdynamik... 3 3.1 Annahmen... 3 3.2 Simulationsdiagramm... 3 3.3 Zeitdiagramm... 4 3.4 Dokumentation
Daisyworld Peter Bützer Inhalt 1 Eine kurze Theorie... 1 2 Aufgabe... 2 3 Simulation, Lösung (Typ 3), Systemdynamik... 3 3.1 Annahmen... 3 3.2 Simulationsdiagramm... 3 3.3 Zeitdiagramm... 4 3.4 Dokumentation
Monod-Kinetik. Peter Bützer
 Monod-Kinetik Peter Bützer Inhalt 1 Einleitung... 1 1.1 Modell... 1 1.2 Modellannahmen... 2 1. Gleichung... 2 1.4 Drei Fälle... 2 Simulation, Systemdynamik... 2.1 Simulationsdiagramm (Typ 1)... 2.2 Dokumentation
Monod-Kinetik Peter Bützer Inhalt 1 Einleitung... 1 1.1 Modell... 1 1.2 Modellannahmen... 2 1. Gleichung... 2 1.4 Drei Fälle... 2 Simulation, Systemdynamik... 2.1 Simulationsdiagramm (Typ 1)... 2.2 Dokumentation
Hefewachstum. Peter Bützer
 Hefewachstum Peter Bützer Inhalt 1 Hefe... 1 2 Das System als Black Box... 2 3 Messung des... 2 4 Modell... 3 5 Simulation (Typ 9)... 3 5.1 Simulationsdiagramm... 4 5.2 Messung... 4 5.3 Dokumentation (Gleichungen,
Hefewachstum Peter Bützer Inhalt 1 Hefe... 1 2 Das System als Black Box... 2 3 Messung des... 2 4 Modell... 3 5 Simulation (Typ 9)... 3 5.1 Simulationsdiagramm... 4 5.2 Messung... 4 5.3 Dokumentation (Gleichungen,
Säureangriff auf die Zähne
 Säureangriff auf die Zähne Eine erfolgreiche Reduktion ist vielleicht die erfolgreichste Form aller wissenschaftlichen Erklärungen, die man sich vorstellen kann. 1 Karl R. Popper, (1902-199) britischer
Säureangriff auf die Zähne Eine erfolgreiche Reduktion ist vielleicht die erfolgreichste Form aller wissenschaftlichen Erklärungen, die man sich vorstellen kann. 1 Karl R. Popper, (1902-199) britischer
Eine Brennstoffzelle, die Umkehr der Wasserelektrolyse
 Wasserelektrolyse Peter Bützer Inhalt Eine Brennstoffzelle, die Umkehr der Wasserelektrolyse 1 Einleitung/Theorie... 1 2 Datenbasis... 2 2.1 Aufgabenstellung... 2 2.2 Durchführung... 2 2.3 Beobachtungen/Messungen...
Wasserelektrolyse Peter Bützer Inhalt Eine Brennstoffzelle, die Umkehr der Wasserelektrolyse 1 Einleitung/Theorie... 1 2 Datenbasis... 2 2.1 Aufgabenstellung... 2 2.2 Durchführung... 2 2.3 Beobachtungen/Messungen...
6. Tag: Chemisches Gleichgewicht und Reaktionskinetik
 6. Tag: Chemisches Gleichgewicht und Reaktionskinetik 1 6. Tag: Chemisches Gleichgewicht und Reaktionskinetik 1. Das chemische Gleichgewicht Eine chemische Reaktion läuft in beiden Richtungen ab. Wenn
6. Tag: Chemisches Gleichgewicht und Reaktionskinetik 1 6. Tag: Chemisches Gleichgewicht und Reaktionskinetik 1. Das chemische Gleichgewicht Eine chemische Reaktion läuft in beiden Richtungen ab. Wenn
Vorlesung Organische Chemie II Reaktionsmechanismen (3. Sem.)
 Vorlesung Organische Chemie II Reaktionsmechanismen (3. Sem.) Gliederung Grundlagen der physikalisch-organischen Chemie Radikalreaktionen Nukleophile und elektrophile Substitution am gesättigten C-Atom
Vorlesung Organische Chemie II Reaktionsmechanismen (3. Sem.) Gliederung Grundlagen der physikalisch-organischen Chemie Radikalreaktionen Nukleophile und elektrophile Substitution am gesättigten C-Atom
Zink, ein wichtiges Spurenelement
 Zink, ein wichtiges Spurenelement Peter Bützer Inhalt 1 Einleitung... 1 2 Aufgaben... 2 3 Lösungen... 3 3.1 Simulationsdiagramm (Typ 1)... 3 3.2 Dokumentation (Gleichungen, Parameter)... 3 3.3 Zeitdiagramm...
Zink, ein wichtiges Spurenelement Peter Bützer Inhalt 1 Einleitung... 1 2 Aufgaben... 2 3 Lösungen... 3 3.1 Simulationsdiagramm (Typ 1)... 3 3.2 Dokumentation (Gleichungen, Parameter)... 3 3.3 Zeitdiagramm...
Sauerstoffbindung im Blut
 Sauerstoffbindung im Blut Die Fähigkeit uns zu wundern, ist das Einzige, was wir brauchen, um gute Philosophen zu werden. Gaarder Jostein, Sofies Welt 1 Inhalt 1 Einleitung/Theorie... 1 2 Aufgabenstellung...
Sauerstoffbindung im Blut Die Fähigkeit uns zu wundern, ist das Einzige, was wir brauchen, um gute Philosophen zu werden. Gaarder Jostein, Sofies Welt 1 Inhalt 1 Einleitung/Theorie... 1 2 Aufgabenstellung...
endotherme Reaktionen
 Exotherme/endotherme endotherme Reaktionen Edukte - H Produkte Exotherme Reaktion Edukte Produkte + H Endotherme Reaktion 101 Das Massenwirkungsgesetz Das Massenwirkungsgesetz Gleichgewicht chemischer
Exotherme/endotherme endotherme Reaktionen Edukte - H Produkte Exotherme Reaktion Edukte Produkte + H Endotherme Reaktion 101 Das Massenwirkungsgesetz Das Massenwirkungsgesetz Gleichgewicht chemischer
Gegenstand der letzten Vorlesung
 Gegenstand der letzten Vorlesung Reaktionsgeschwindigkeit Reaktionsordnung Molekularität Reaktion 0., 1.,. Ordnung Reaktion pseudo-erster Ordnung Aktivierungsenergie Temperaturabhängigkeit der Geschwindigkeitskonstanten
Gegenstand der letzten Vorlesung Reaktionsgeschwindigkeit Reaktionsordnung Molekularität Reaktion 0., 1.,. Ordnung Reaktion pseudo-erster Ordnung Aktivierungsenergie Temperaturabhängigkeit der Geschwindigkeitskonstanten
Indigokarmin, Indigotin - Metabolismus
 Indigokarmin, Indigotin - Metabolismus Inhalt 1.1 Chemische Charakterisierung,... 1 1.2 Verwendung und physiologische Eigenschaften... 3 1.3 Simulation des Metabolismus (Simulations-Typ 4), Systemdynamik...
Indigokarmin, Indigotin - Metabolismus Inhalt 1.1 Chemische Charakterisierung,... 1 1.2 Verwendung und physiologische Eigenschaften... 3 1.3 Simulation des Metabolismus (Simulations-Typ 4), Systemdynamik...
2. Chemische Reaktionen und chemisches Gleichgewicht
 2. Chemische Reaktionen und chemisches Gleichgewicht 2.1 Enthalpie (ΔH) Bei chemischen Reaktionen reagieren die Edukte zu Produkten. Diese unterscheiden sich in der inneren Energie. Es gibt dabei zwei
2. Chemische Reaktionen und chemisches Gleichgewicht 2.1 Enthalpie (ΔH) Bei chemischen Reaktionen reagieren die Edukte zu Produkten. Diese unterscheiden sich in der inneren Energie. Es gibt dabei zwei
Homogenes Gleichgewicht
 Knoch, Anastasiya Datum der Durchführung: Petri, Guido 08.12.2015 (Gruppe 11) Datum der Korrektur: 02.02.2016 Praktikum Physikalische Chemie I. Thermodynamik Homogenes Gleichgewicht 1. Aufgabenstellung
Knoch, Anastasiya Datum der Durchführung: Petri, Guido 08.12.2015 (Gruppe 11) Datum der Korrektur: 02.02.2016 Praktikum Physikalische Chemie I. Thermodynamik Homogenes Gleichgewicht 1. Aufgabenstellung
Praktische Einführung in die Chemie Integriertes Praktikum:
 Praktische Einführung in die Chemie Integriertes Praktikum: Versuch 1-2 (MWG) Massenwirkungsgesetz Versuchs-Datum: 20. Juni 2012 Gruppenummer: 8 Gruppenmitglieder: Domenico Paone Patrick Küssner Michael
Praktische Einführung in die Chemie Integriertes Praktikum: Versuch 1-2 (MWG) Massenwirkungsgesetz Versuchs-Datum: 20. Juni 2012 Gruppenummer: 8 Gruppenmitglieder: Domenico Paone Patrick Küssner Michael
Probleme sind Gelegenheiten zu zeigen, was man kann. Duke Ellington, amerikanischer Jazz-Musiker (1899-1974)
 1 H 2 -Atemtest (Lactose-Toleranztest) Inhalt Probleme sind Gelegenheiten zu zeigen, was man kann. Duke Ellington, amerikanischer Jazz-Musiker (1899-1974) 1 Lactose-Intoleranz: Einführung... 1 2 Wasserstoff...
1 H 2 -Atemtest (Lactose-Toleranztest) Inhalt Probleme sind Gelegenheiten zu zeigen, was man kann. Duke Ellington, amerikanischer Jazz-Musiker (1899-1974) 1 Lactose-Intoleranz: Einführung... 1 2 Wasserstoff...
Stoffwechsel bei Mehlkäferlarven
 Stoffwechsel bei Mehlkäferlarven Franziskus Graber, Peter Bützer 1 Inhalt 1 Einleitung... 1 2 Warum gerade der Mehlwurm als Versuchstier?... 2 3 Das Experiment... 2 3.1 Einige Bilder von Mehlkäferlarven...
Stoffwechsel bei Mehlkäferlarven Franziskus Graber, Peter Bützer 1 Inhalt 1 Einleitung... 1 2 Warum gerade der Mehlwurm als Versuchstier?... 2 3 Das Experiment... 2 3.1 Einige Bilder von Mehlkäferlarven...
Buch Nr. Standort Buchtitel Auflage Autor Verlag Jahr Sprache Allgemeine Chemie - Grundkurs
 Buch Nr. Standort Buchtitel Auflage Autor Verlag Jahr Sprache Allgemeine Chemie - Grundkurs 1 Teil 1 Pscheidel Wissenschaften 1975 Deutsch 2 Allgemeine Chemie - Grundkurs Teil 2 Pscheidel Wissenschaften
Buch Nr. Standort Buchtitel Auflage Autor Verlag Jahr Sprache Allgemeine Chemie - Grundkurs 1 Teil 1 Pscheidel Wissenschaften 1975 Deutsch 2 Allgemeine Chemie - Grundkurs Teil 2 Pscheidel Wissenschaften
Klausur Physikalische Chemie für TUHH (Chemie III)
 07.03.2012 14.00 Uhr 17.00 Uhr Moritz / Pauer Klausur Physikalische Chemie für TUHH (Chemie III) Die folgende Tabelle dient Korrekturzwecken und darf vom Studenten nicht ausgefüllt werden. 1 2 3 4 5 6
07.03.2012 14.00 Uhr 17.00 Uhr Moritz / Pauer Klausur Physikalische Chemie für TUHH (Chemie III) Die folgende Tabelle dient Korrekturzwecken und darf vom Studenten nicht ausgefüllt werden. 1 2 3 4 5 6
Praktikum. Enzymkinetik am Beispiel der Protease Trypsin
 Praktikum Methoden der molekularen Biowissenschaften Teil 1: Biochemie Enzymkinetik am Beispiel der Protease Trypsin Prof. Walter Nickel Biochemie-Zentrum der Universität Heidelberg Thermodynamische Eigenschaften
Praktikum Methoden der molekularen Biowissenschaften Teil 1: Biochemie Enzymkinetik am Beispiel der Protease Trypsin Prof. Walter Nickel Biochemie-Zentrum der Universität Heidelberg Thermodynamische Eigenschaften
Grundlagen der Chemie Verschieben von Gleichgewichten
 Verschieben von Gleichgewichten Prof. Annie Powell KIT Universität des Landes Baden-Württemberg und nationales Forschungszentrum in der Helmholtz-Gemeinschaft www.kit.edu Prinzip des kleinsten Zwangs Das
Verschieben von Gleichgewichten Prof. Annie Powell KIT Universität des Landes Baden-Württemberg und nationales Forschungszentrum in der Helmholtz-Gemeinschaft www.kit.edu Prinzip des kleinsten Zwangs Das
c C 2 K = c A 2 c B 2mol /l 2 0,5mol /l 2 4 mol /l K =4l /mol
 Berechnungen zum Massenwirkungsgesetz 1/13 Jakob 2010 Fall 1a: Gegeben: Gleichgewichtskonzentrationen aller Stoffe; Gesucht: Gleichgewichtskonstante Die Reaktion 2A + B 2C befindet sich im Gleichgewicht.
Berechnungen zum Massenwirkungsgesetz 1/13 Jakob 2010 Fall 1a: Gegeben: Gleichgewichtskonzentrationen aller Stoffe; Gesucht: Gleichgewichtskonstante Die Reaktion 2A + B 2C befindet sich im Gleichgewicht.
Übungsaufgaben Physikalische Chemie
 Gleichgewichte: Übungsaufgaben Physikalische Chemie F1. Stellen Sie die Ausdrücke für die Gleichgewichtskonstanten folgender Reaktionen auf: a) CO (g) + Cl 2 (g) COCl (g) + Cl(g) b) 2 SO 2 (g) + O 2 (g)
Gleichgewichte: Übungsaufgaben Physikalische Chemie F1. Stellen Sie die Ausdrücke für die Gleichgewichtskonstanten folgender Reaktionen auf: a) CO (g) + Cl 2 (g) COCl (g) + Cl(g) b) 2 SO 2 (g) + O 2 (g)
Wasserstoffbrückenbindung, H 2 O, NH 3, HF, Wasserstoff im PSE, Isotope, Vorkommen, exotherme Reaktion mit Sauerstoff zu Wasser, Energieinhalt,
 Wiederholung der letzten Vorlesungsstunde: Das Element Wasserstoff und seine Verbindungen Wasserstoffbrückenbindung, H 2 O, NH 3, HF, Wasserstoff im PSE, Isotope, Vorkommen, exotherme Reaktion mit Sauerstoff
Wiederholung der letzten Vorlesungsstunde: Das Element Wasserstoff und seine Verbindungen Wasserstoffbrückenbindung, H 2 O, NH 3, HF, Wasserstoff im PSE, Isotope, Vorkommen, exotherme Reaktion mit Sauerstoff
Die elektrophile Addition
 Die elektrophile Addition Roland Heynkes 3.10.2005, Aachen Die elektrophile Addition als typische Reaktion der Doppelbindung in Alkenen bietet einen Einstieg in die Welt der organisch-chemischen Reaktionsmechanismen.
Die elektrophile Addition Roland Heynkes 3.10.2005, Aachen Die elektrophile Addition als typische Reaktion der Doppelbindung in Alkenen bietet einen Einstieg in die Welt der organisch-chemischen Reaktionsmechanismen.
VERSUCH 16 CHEMISCHES GLEICHGEWICHT IN DER GASPHASE
 GRUNDPRAKTIKUM PHYSIKALISCHE CHEMIE VERSUCH 16 CHEMISCHES GLEICHGEWICHT IN DER GASPHASE Kurzbeschreibung: Die Temperaturabhängigkeit des chemischen Gasphasen-Gleichgewichts wird unter isobaren Bedingungen
GRUNDPRAKTIKUM PHYSIKALISCHE CHEMIE VERSUCH 16 CHEMISCHES GLEICHGEWICHT IN DER GASPHASE Kurzbeschreibung: Die Temperaturabhängigkeit des chemischen Gasphasen-Gleichgewichts wird unter isobaren Bedingungen
Einführung in die Physikalische Chemie Teil 1: Mikrostruktur der Materie
 Einführung in die Physikalische Chemie Teil 1: Mikrostruktur der Materie Kapitel 1: Quantenmechanik Kapitel 2: Atome Kapitel 3: Moleküle Mathematische Grundlagen Schrödingergleichung Einfache Beispiele
Einführung in die Physikalische Chemie Teil 1: Mikrostruktur der Materie Kapitel 1: Quantenmechanik Kapitel 2: Atome Kapitel 3: Moleküle Mathematische Grundlagen Schrödingergleichung Einfache Beispiele
3.4 Energieumsatz bei Reaktionen
 3.4 Energieumsatz bei Reaktionen Versuch: Verbrennen eines Stückes Holz Beobachtung: Energie wird freigesetzt in Form von Wärme. Jede Reaktion ist mit einem Energieumsatz gekoppelt. Reaktionen, bei denen
3.4 Energieumsatz bei Reaktionen Versuch: Verbrennen eines Stückes Holz Beobachtung: Energie wird freigesetzt in Form von Wärme. Jede Reaktion ist mit einem Energieumsatz gekoppelt. Reaktionen, bei denen
Bestimmung von thermodynamischen Daten aus elektrochemischen Messungen. Temperaturabhängigkeit der EMK
 V7 Bestimmung von thermodynamischen Daten aus elektrochemischen Messungen Temperaturabhängigkeit der EMK Versuch 7: Bestimmung von thermodynamischen Daten aus elektrochemischen Messungen. Temperaturabhängigkeit
V7 Bestimmung von thermodynamischen Daten aus elektrochemischen Messungen Temperaturabhängigkeit der EMK Versuch 7: Bestimmung von thermodynamischen Daten aus elektrochemischen Messungen. Temperaturabhängigkeit
Richtung chemischer Reaktionen, Chemisches Gleichgewicht. Massenwirkungsgesetz
 Richtung chemischer Reaktionen, Chemisches Gleichgewicht a A + b B K = [C] [A] c a [D] [B] c C + d D d b Massenwirkungsgesetz K = Gleichgewichtskonstante [ ] = in Lösung: Konzentration (in mol L -1 ),
Richtung chemischer Reaktionen, Chemisches Gleichgewicht a A + b B K = [C] [A] c a [D] [B] c C + d D d b Massenwirkungsgesetz K = Gleichgewichtskonstante [ ] = in Lösung: Konzentration (in mol L -1 ),
Protokoll Dampfdruck. Punkte: /10
 Protokoll Dampfdruck Gruppe Biologie Assistent: Olivier Evelyn Jähne, Eva Eickmeier, Claudia Keller Kontakt: [email protected] Sommersemester 2006 6. Juni 2006 Punkte: /0 . Einleitung Wenn eine
Protokoll Dampfdruck Gruppe Biologie Assistent: Olivier Evelyn Jähne, Eva Eickmeier, Claudia Keller Kontakt: [email protected] Sommersemester 2006 6. Juni 2006 Punkte: /0 . Einleitung Wenn eine
7. Tag: Säuren und Basen
 7. Tag: Säuren und Basen 1 7. Tag: Säuren und Basen 1. Definitionen für Säuren und Basen In früheren Zeiten wußte man nicht genau, was eine Säure und was eine Base ist. Damals wurde eine Säure als ein
7. Tag: Säuren und Basen 1 7. Tag: Säuren und Basen 1. Definitionen für Säuren und Basen In früheren Zeiten wußte man nicht genau, was eine Säure und was eine Base ist. Damals wurde eine Säure als ein
ABTEILUNG CHEMIE Laboranten Lehrjahr ANORGANISCHE CHEMIE St. Magyar/ A. Soi S t o f f p l a n Laborant/in Fachrichtung Chemie
 Beruf: Fach: Laborant/in Fachrichtung Chemie Allgemeine und Anorganische Chemie S t o f f p l a n Bildungsverordnung vom: Semester: 1-6 Lektionen: 210 Lehrmittel: Elemente ISBN 978-3-264-83645-5 1.8.2008
Beruf: Fach: Laborant/in Fachrichtung Chemie Allgemeine und Anorganische Chemie S t o f f p l a n Bildungsverordnung vom: Semester: 1-6 Lektionen: 210 Lehrmittel: Elemente ISBN 978-3-264-83645-5 1.8.2008
Organische Chemie 1 Teil 2 1. Vorlesung, Dienstag
 Inhalte der 1. Vorlesung: 1. Die Reaktivität organischer Moleküle 1.1 Warum geschehen Chemische Reaktionen 1.2 Gleichgewichtsreaktionen, Ungleichgewichtsreaktionen 1.2.1 Triebkraft chemischer Reaktionen
Inhalte der 1. Vorlesung: 1. Die Reaktivität organischer Moleküle 1.1 Warum geschehen Chemische Reaktionen 1.2 Gleichgewichtsreaktionen, Ungleichgewichtsreaktionen 1.2.1 Triebkraft chemischer Reaktionen
[Co(NH 3 ) 2 (H 2 O) 2 ] 3+
![[Co(NH 3 ) 2 (H 2 O) 2 ] 3+ [Co(NH 3 ) 2 (H 2 O) 2 ] 3+](/thumbs/33/16366221.jpg) Kap. 7.3 Das Massenwirkungsgesetz Frage 121 Kap. 7.3 Das Massenwirkungsgesetz Antwort 121 Schreiben Sie das Massenwirkungsgesetz (MWG) für die folgende Reaktion auf: Fe 3+ (aq) + 3 SCN - (aq) Fe(SCN) 3
Kap. 7.3 Das Massenwirkungsgesetz Frage 121 Kap. 7.3 Das Massenwirkungsgesetz Antwort 121 Schreiben Sie das Massenwirkungsgesetz (MWG) für die folgende Reaktion auf: Fe 3+ (aq) + 3 SCN - (aq) Fe(SCN) 3
Kapitel 3 Alkene Struktur, Nomenklatur, Reaktivität Thermodynamik und Kinetik
 Kapitel 3 Alkene Struktur, Nomenklatur, Reaktivität Thermodynamik und Kinetik 34 Geben Sie die systematischen Namen jeder der folgenden Verbindungen an: Welche der Verbindungen aus Übung besitzen E- und
Kapitel 3 Alkene Struktur, Nomenklatur, Reaktivität Thermodynamik und Kinetik 34 Geben Sie die systematischen Namen jeder der folgenden Verbindungen an: Welche der Verbindungen aus Übung besitzen E- und
Übungen zur VL Chemie für Biologen und Humanbiologen 05.12.2011 Lösung Übung 6
 Übungen zur VL Chemie für Biologen und Humanbiologen 05.12.2011 Lösung Übung 6 Thermodynamik und Gleichgewichte 1. a) Was sagt die Enthalpie aus? Die Enthalpie H beschreibt den Energiegehalt von Materie
Übungen zur VL Chemie für Biologen und Humanbiologen 05.12.2011 Lösung Übung 6 Thermodynamik und Gleichgewichte 1. a) Was sagt die Enthalpie aus? Die Enthalpie H beschreibt den Energiegehalt von Materie
Tabellen und Formelsammlung Chemie
 Tabellen und Forelsalung Cheie Fakultät Maschinenbau Stand SS 2015 Nachfolgende Tabellen und Inforationen staen aus de Lehrbuch G. Kickelbick, Cheie für Ingenieure, Pearson-Verlag, 2008 soweit nicht anderweitig
Tabellen und Forelsalung Cheie Fakultät Maschinenbau Stand SS 2015 Nachfolgende Tabellen und Inforationen staen aus de Lehrbuch G. Kickelbick, Cheie für Ingenieure, Pearson-Verlag, 2008 soweit nicht anderweitig
4.3 Reaktionsgeschwindigkeit und Katalysator
 4.3 Reaktionsgeschwindigkeit und Katalysator Neben der thermodynamischen Lage des chemischen Gleichgewichts ist der zeitliche Ablauf der Reaktion, also die Geschwindigkeit der Einstellung des Gleichgewichts,
4.3 Reaktionsgeschwindigkeit und Katalysator Neben der thermodynamischen Lage des chemischen Gleichgewichts ist der zeitliche Ablauf der Reaktion, also die Geschwindigkeit der Einstellung des Gleichgewichts,
Lösungen (ohne Aufgabenstellungen)
 Kapitel 1 Das chemische Gleichgewicht Lösungen (ohne Aufgabenstellungen) Aufgaben A 1 Die Hin- und die Rückreaktion läuft nach der Einstellung des Gleichgewichts mit derselben Geschwindigkeit ab, d. h.
Kapitel 1 Das chemische Gleichgewicht Lösungen (ohne Aufgabenstellungen) Aufgaben A 1 Die Hin- und die Rückreaktion läuft nach der Einstellung des Gleichgewichts mit derselben Geschwindigkeit ab, d. h.
1) Ein offenes System zeichnet sich immer durch eine konstante Temperatur aus. zeichnet sich immer durch eine konstante Masse aus.
 1) Ein offenes System zeichnet sich immer durch eine konstante Temperatur aus. zeichnet sich immer durch eine konstante Masse aus. kann mit der Umgebung Energie austauschen. kann mit der Umgebung Entropie
1) Ein offenes System zeichnet sich immer durch eine konstante Temperatur aus. zeichnet sich immer durch eine konstante Masse aus. kann mit der Umgebung Energie austauschen. kann mit der Umgebung Entropie
Grundlagen der Chemie
 1 Das Massenwirkungsgesetz Verschiebung von Gleichgewichtslagen Metastabile Systeme/Katalysatoren Löslichkeitsprodukt Das Massenwirkungsgesetz Wenn Substanzen miteinander eine reversible chemische Reaktion
1 Das Massenwirkungsgesetz Verschiebung von Gleichgewichtslagen Metastabile Systeme/Katalysatoren Löslichkeitsprodukt Das Massenwirkungsgesetz Wenn Substanzen miteinander eine reversible chemische Reaktion
Basiswissen Chemie. Vorkurs des MINTroduce-Projekts
 Basiswissen Chemie Vorkurs des MINTroduce-Projekts Christoph Wölper [email protected] Sprechzeiten (Raum: S07 S00 C24 oder S07 S00 D27) Was bislang geschah Kinetik Reaktionsgeschwindigkeit Konzentrationsabhängigkeit
Basiswissen Chemie Vorkurs des MINTroduce-Projekts Christoph Wölper [email protected] Sprechzeiten (Raum: S07 S00 C24 oder S07 S00 D27) Was bislang geschah Kinetik Reaktionsgeschwindigkeit Konzentrationsabhängigkeit
Chemie am Friedrich-Leopold-Woeste-Gymnasium Hemer
 Einführungsphase Unterrichtsvorhaben III Thema/Kontext: Methoden der Kalkentfernung im Haushalt Basiskonzepte (Schwerpunkt): Basiskonzept Chemisches Gleichgewicht / Basiskonzept Energie Schwerpunkte übergeordneter
Einführungsphase Unterrichtsvorhaben III Thema/Kontext: Methoden der Kalkentfernung im Haushalt Basiskonzepte (Schwerpunkt): Basiskonzept Chemisches Gleichgewicht / Basiskonzept Energie Schwerpunkte übergeordneter
Klausur zur Vorlesung "Allgemeine Chemie " am
 1 2 3 4 5 6 7 8 9 10 11 12 13 14 Σ Klausur zur Vorlesung "Allgemeine Chemie " am 08.02.2007 Name: Vorname: Matr.-Nr. Studiengang: Platz.-Nr. Hinweise für die Bearbeitung der Aufgaben 1) Hilfsmittel außer
1 2 3 4 5 6 7 8 9 10 11 12 13 14 Σ Klausur zur Vorlesung "Allgemeine Chemie " am 08.02.2007 Name: Vorname: Matr.-Nr. Studiengang: Platz.-Nr. Hinweise für die Bearbeitung der Aufgaben 1) Hilfsmittel außer
Phasengleichgewicht. 1. Experimentelle Bestimmung des Dampfdrucks von Methanol als Funktion der Temperatur. A fl. A g
 Physikalisch-Chemische Praktika Phasengleichgewicht Versuch T-2 Aufgaben 1. Experimentelle Bestimmung des Dampfdrucks von Methanol als Funktion der Temperatur. 2. Ermittlung der Phasenumwandlungsenthalpie
Physikalisch-Chemische Praktika Phasengleichgewicht Versuch T-2 Aufgaben 1. Experimentelle Bestimmung des Dampfdrucks von Methanol als Funktion der Temperatur. 2. Ermittlung der Phasenumwandlungsenthalpie
Basiskenntnistest - Chemie
 Basiskenntnistest - Chemie 1.) Welche Aussage trifft auf Alkohole zu? a. ) Die funktionelle Gruppe der Alkohole ist die Hydroxygruppe. b. ) Alle Alkohole sind ungiftig. c. ) Mehrwertige Alkohole werden
Basiskenntnistest - Chemie 1.) Welche Aussage trifft auf Alkohole zu? a. ) Die funktionelle Gruppe der Alkohole ist die Hydroxygruppe. b. ) Alle Alkohole sind ungiftig. c. ) Mehrwertige Alkohole werden
Zementhärtung. Peter Bützer
 Zementhärtung Peter Bützer Vollkommenheit entsteht offensichtlich nicht dann, wenn man nichts mehr hinzuzufügen hat, sondern, wenn man nichts mehr wegnehmen kann. Antoine de Saint-Exupéry, französischer
Zementhärtung Peter Bützer Vollkommenheit entsteht offensichtlich nicht dann, wenn man nichts mehr hinzuzufügen hat, sondern, wenn man nichts mehr wegnehmen kann. Antoine de Saint-Exupéry, französischer
Musterklausur 1 zur Allgemeinen und Anorganischen Chemie
 Musterklausur 1 zur Allgemeinen und Anorganischen Chemie Achtung: Taschenrechner ist nicht zugelassen. Aufgaben sind so, dass sie ohne Rechner lösbar sind. Weitere Hilfsmittel: Periodensystem der Elemente
Musterklausur 1 zur Allgemeinen und Anorganischen Chemie Achtung: Taschenrechner ist nicht zugelassen. Aufgaben sind so, dass sie ohne Rechner lösbar sind. Weitere Hilfsmittel: Periodensystem der Elemente
3.1. Fragen zum chemischen Gleichgewicht
 .1. Fragen zum chemischen Gleichgewicht Reaktionsgeschwindigkeiten (5) Beschreibe die Reaktion von Salzsäure HCl mit Magnesium Mg mit einer Reaktionsgleichung und gib den Reaktionstyp an. () Verwendet
.1. Fragen zum chemischen Gleichgewicht Reaktionsgeschwindigkeiten (5) Beschreibe die Reaktion von Salzsäure HCl mit Magnesium Mg mit einer Reaktionsgleichung und gib den Reaktionstyp an. () Verwendet
Kettenreaktionen. Kapitel 2. In diesem Kapitel sollen die folgenden Fragen beantwortet werden:
 Kapitel 2 Kettenreaktionen In diesem Kapitel sollen die folgenden Fragen beantwortet werden: Was versteht man unter einer Kettenreaktion? Welches sind die verschiedenen Typen von Reaktionsschritten, die
Kapitel 2 Kettenreaktionen In diesem Kapitel sollen die folgenden Fragen beantwortet werden: Was versteht man unter einer Kettenreaktion? Welches sind die verschiedenen Typen von Reaktionsschritten, die
Fragen zum Thema chemische Reaktionen Klasse 4 1. Was gehört zu einer chemische Reaktionsgleichung? 2. Wie nennt man die Stoffe, die vor der Reaktion
 1. Was gehört zu einer chemische Reaktionsgleichung? 2. Wie nennt man die Stoffe, die vor der Reaktion vorliegen? 3. Wie nennt man die Stoffe, die nach der Reaktion vorliegen? 4. Womit wird die Richtung
1. Was gehört zu einer chemische Reaktionsgleichung? 2. Wie nennt man die Stoffe, die vor der Reaktion vorliegen? 3. Wie nennt man die Stoffe, die nach der Reaktion vorliegen? 4. Womit wird die Richtung
Eine Runaway-Reaktion
 Eine Runaway-Reaktion Peter Bützer, Markus Roth Inhalt 0H1 1H2 2H3 3H4 8H5 15H6 17H7 18H8 19H9 20H10 Dynamik in der Chemie... 21H1 Schritte der Systemdynamik... 22H2 Ein Katalysator... 23H3 Das Experiment...
Eine Runaway-Reaktion Peter Bützer, Markus Roth Inhalt 0H1 1H2 2H3 3H4 8H5 15H6 17H7 18H8 19H9 20H10 Dynamik in der Chemie... 21H1 Schritte der Systemdynamik... 22H2 Ein Katalysator... 23H3 Das Experiment...
2. Teilklausur zum Chemischen Grundpraktikum im WS 2015/16 vom
 2. Teilklausur zum Chemischen Grundpraktikum im WS 2015/16 vom 20.01.2016 A1 A2 A3 F4 R5 E6 Note 10 9 6 8 9 8 50 NAME/VORNAME:... Matrikelnummer:... Pseudonym für Ergebnisveröffentlichung Schreiben Sie
2. Teilklausur zum Chemischen Grundpraktikum im WS 2015/16 vom 20.01.2016 A1 A2 A3 F4 R5 E6 Note 10 9 6 8 9 8 50 NAME/VORNAME:... Matrikelnummer:... Pseudonym für Ergebnisveröffentlichung Schreiben Sie
Säuren und Basen. Dr. Torsten Beweries AC I - Allgemeine Chemie LAC-CH01 WS 2016/17.
 Säuren und Basen Dr. Torsten Beweries AC I - Allgemeine Chemie LAC-CH01 WS 2016/17 [email protected] http://www.catalysis.de/forschung/koordinationschemische-katalyse/koordinationschemische-wasserspaltung/
Säuren und Basen Dr. Torsten Beweries AC I - Allgemeine Chemie LAC-CH01 WS 2016/17 [email protected] http://www.catalysis.de/forschung/koordinationschemische-katalyse/koordinationschemische-wasserspaltung/
Basiswissen Chemie. Vorkurs des MINTroduce-Projekts
 Basiswissen Chemie Vorkurs des MINTroduce-Projekts Christoph Wölper [email protected] Sprechzeiten (Raum: S07 S00 C24 oder S07 S00 D27) Teilnahmebescheinigungen Mail an [email protected]
Basiswissen Chemie Vorkurs des MINTroduce-Projekts Christoph Wölper [email protected] Sprechzeiten (Raum: S07 S00 C24 oder S07 S00 D27) Teilnahmebescheinigungen Mail an [email protected]
Hybridorbitale und ihre Bedeutung
 Hybridorbitale und ihre Bedeutung Roland Heynkes 27.4.2005, Aachen Die Chemie wird kaum von den Atomkernen und den inneren Elektronenschalen, sondern hauptsächlich von der jeweils äußersten Elektronenschale
Hybridorbitale und ihre Bedeutung Roland Heynkes 27.4.2005, Aachen Die Chemie wird kaum von den Atomkernen und den inneren Elektronenschalen, sondern hauptsächlich von der jeweils äußersten Elektronenschale
Mefenaminsäure 2-(2,3-Dimethylanilino)benzoesäure,
 Mefenaminsäure 2-(2,3-Dimethylanilino)benzoesäure, Peter Bützer Inhalt 1 Chemische Charakterisierung... 1 2 Markennamen... 2 3 Galenische Form, Wirkstoffmenge pro Dosis... 2 4 Wirkung... 2 5 Indikationen/Anwendungen...
Mefenaminsäure 2-(2,3-Dimethylanilino)benzoesäure, Peter Bützer Inhalt 1 Chemische Charakterisierung... 1 2 Markennamen... 2 3 Galenische Form, Wirkstoffmenge pro Dosis... 2 4 Wirkung... 2 5 Indikationen/Anwendungen...
Das Chemische Gleichgewicht
 Das Chemische Gleichgewicht Geschwindigkeit der Hinreaktion: v hin = k hin c(a 2 ) c(x 2 ) Geschwindigkeit der Rückreaktion: v rück = k rück c 2 (AX) Gleichgewicht: v hin = v rück k hin c(a 2 ) c(x 2 )
Das Chemische Gleichgewicht Geschwindigkeit der Hinreaktion: v hin = k hin c(a 2 ) c(x 2 ) Geschwindigkeit der Rückreaktion: v rück = k rück c 2 (AX) Gleichgewicht: v hin = v rück k hin c(a 2 ) c(x 2 )
Endersch, Jonas Praktikum Allgemeine Chemie 2, Saal G1, Platz 53
 Endersch, Jonas 30.06.2008 Praktikum Allgemeine Chemie 2, Saal G1, Platz 53 Versuchsprotokoll Versuch 2.5a: Herstellung von Cholesterylbenzoat Reaktionsgleichung: Einleitung und Theorie: In diesem Versuch
Endersch, Jonas 30.06.2008 Praktikum Allgemeine Chemie 2, Saal G1, Platz 53 Versuchsprotokoll Versuch 2.5a: Herstellung von Cholesterylbenzoat Reaktionsgleichung: Einleitung und Theorie: In diesem Versuch
Thermodynamik. Thermodynamik
 Geschlossenes System: Energieaustausch, aber kein Materieaustausch mit der Umgebung. Innere Energie: Jeder Stoff hat in sich Energie in irgendeiner Form gespeichert: die innere Energie U. U 1 = innere
Geschlossenes System: Energieaustausch, aber kein Materieaustausch mit der Umgebung. Innere Energie: Jeder Stoff hat in sich Energie in irgendeiner Form gespeichert: die innere Energie U. U 1 = innere
1 Chemische Elemente und chemische Grundgesetze
 1 Chemische Elemente und chemische Grundgesetze Die Chemie ist eine naturwissenschaftliche Disziplin. Sie befasst sich mit der Zusammensetzung, Charakterisierung und Umwandlung von Materie. Unter Materie
1 Chemische Elemente und chemische Grundgesetze Die Chemie ist eine naturwissenschaftliche Disziplin. Sie befasst sich mit der Zusammensetzung, Charakterisierung und Umwandlung von Materie. Unter Materie
14 Massenwirkungsgesetz
 14 Massenwirkungsgesetz Im vorherigen Abschnitt haben wir uns mit der Mischungsentroie beschäftigt, die aber nur einen Asekt der Mischung von idealen Gasen berücksichtigt, nämlich des Mischens und rennens
14 Massenwirkungsgesetz Im vorherigen Abschnitt haben wir uns mit der Mischungsentroie beschäftigt, die aber nur einen Asekt der Mischung von idealen Gasen berücksichtigt, nämlich des Mischens und rennens
Bindung in Kohlenwasserstoffmolekülen
 Bindung in Kohlenwasserstoffmolekülen Die Kohlenstoffbindungen im Vergleich Bindung Bindungsstärke Differenz Bindungslänge [kj/mol] [pm] H-H 430 74 C-H 413-17 109 C-C 348 154 C=C 614 + 266 134 C C 839
Bindung in Kohlenwasserstoffmolekülen Die Kohlenstoffbindungen im Vergleich Bindung Bindungsstärke Differenz Bindungslänge [kj/mol] [pm] H-H 430 74 C-H 413-17 109 C-C 348 154 C=C 614 + 266 134 C C 839
Bioorganische Chemie Enzymatische Katalyse 2011
 Ringvorlesung Chemie B - Studiengang Molekulare Biotechnologie Bioorganische Chemie Enzymatische Katalyse 2011 Prof. Dr. A. Jäschke INF 364, Zi. 308, Tel. 54 48 51 [email protected] Lehrziele I Kenntnis
Ringvorlesung Chemie B - Studiengang Molekulare Biotechnologie Bioorganische Chemie Enzymatische Katalyse 2011 Prof. Dr. A. Jäschke INF 364, Zi. 308, Tel. 54 48 51 [email protected] Lehrziele I Kenntnis
Kapitel 4. Die Grundlagen der Kinetik
 Kapitel 4. Die Grundlagen der Kinetik Monomolekulare Reaktion erster rdnung A Produkte; v = k [A] (S N 1) bimolekulare Reaktion zweiter rdnung (S N 2) A + B Produkte; v = k [A] [B] Einfluss der Aktivierungsbarrieren
Kapitel 4. Die Grundlagen der Kinetik Monomolekulare Reaktion erster rdnung A Produkte; v = k [A] (S N 1) bimolekulare Reaktion zweiter rdnung (S N 2) A + B Produkte; v = k [A] [B] Einfluss der Aktivierungsbarrieren
Thermodynamik & Kinetik
 Thermodynamik & Kinetik Inhaltsverzeichnis Ihr versteht die Begriffe offenes System, geschlossenes System, isoliertes System, Enthalpie, exotherm und endotherm... 3 Ihr kennt die Funktionsweise eines Kalorimeters
Thermodynamik & Kinetik Inhaltsverzeichnis Ihr versteht die Begriffe offenes System, geschlossenes System, isoliertes System, Enthalpie, exotherm und endotherm... 3 Ihr kennt die Funktionsweise eines Kalorimeters
1/37. Das Protolysegleichgewicht. Wie könnte man die Stärke einer Säure quantitativ definieren?
 Das Protolysegleichgewicht 1/37 Wie könnte man die Stärke einer Säure quantitativ definieren? Das Protolysegleichgewicht 2/37 Wie könnte man die Stärke einer Säure quantitativ definieren? Ein erster Ansatz
Das Protolysegleichgewicht 1/37 Wie könnte man die Stärke einer Säure quantitativ definieren? Das Protolysegleichgewicht 2/37 Wie könnte man die Stärke einer Säure quantitativ definieren? Ein erster Ansatz
Roland Reich. Thermodynamik. Grundlagen und Anwendungen in der allgemeinen Chemie. Zweite, verbesserte Auflage VCH. Weinheim New York Basel Cambridge
 Roland Reich Thermodynamik Grundlagen und Anwendungen in der allgemeinen Chemie Zweite, verbesserte Auflage VCH Weinheim New York Basel Cambridge Inhaltsverzeichnis Formelzeichen Maßeinheiten XV XX 1.
Roland Reich Thermodynamik Grundlagen und Anwendungen in der allgemeinen Chemie Zweite, verbesserte Auflage VCH Weinheim New York Basel Cambridge Inhaltsverzeichnis Formelzeichen Maßeinheiten XV XX 1.
Kompendium der allgemeinen und anorganischen Chemie
 Kompendium der allgemeinen und anorganischen Chemie Von Dr. rer. nat. habil. Peter Hermann Wissenschaftlicher Oberassistent am Physiologisch-Chemischen Institut der Martin-Luther-Universität Halle-Wittenberg
Kompendium der allgemeinen und anorganischen Chemie Von Dr. rer. nat. habil. Peter Hermann Wissenschaftlicher Oberassistent am Physiologisch-Chemischen Institut der Martin-Luther-Universität Halle-Wittenberg
Arnold Arni. Grundkurs Chemie. unter Mitarbeit von Klaus Neuenschwander VCH. Weinheim New York Basel Cambridge
 Arnold Arni Grundkurs Chemie unter Mitarbeit von Klaus Neuenschwander VCH Weinheim New York Basel Cambridge Inhaltsverzeichnis Grundkurs Chemie (Allgemeine Chemie) 11 Kapitel 1: Das Periodensystem der
Arnold Arni Grundkurs Chemie unter Mitarbeit von Klaus Neuenschwander VCH Weinheim New York Basel Cambridge Inhaltsverzeichnis Grundkurs Chemie (Allgemeine Chemie) 11 Kapitel 1: Das Periodensystem der
Thermodynamik. Thermodynamik ist die Lehre von den Energieänderungen im Verlauf von physikalischen und chemischen Vorgängen.
 Thermodynamik Was ist das? Thermodynamik ist die Lehre von den Energieänderungen im Verlauf von physikalischen und chemischen Vorgängen. Gesetze der Thermodynamik Erlauben die Voraussage, ob eine bestimmte
Thermodynamik Was ist das? Thermodynamik ist die Lehre von den Energieänderungen im Verlauf von physikalischen und chemischen Vorgängen. Gesetze der Thermodynamik Erlauben die Voraussage, ob eine bestimmte
a) Welche der folgenden Aussagen treffen nicht zu? (Dies bezieht sind nur auf Aufgabenteil a)
 Aufgabe 1: Multiple Choice (10P) Geben Sie an, welche der Aussagen richtig sind. Unabhängig von der Form der Fragestellung (Singular oder Plural) können eine oder mehrere Antworten richtig sein. a) Welche
Aufgabe 1: Multiple Choice (10P) Geben Sie an, welche der Aussagen richtig sind. Unabhängig von der Form der Fragestellung (Singular oder Plural) können eine oder mehrere Antworten richtig sein. a) Welche
Physik für Mediziner im 1. Fachsemester
 Physik für Mediziner im 1. Fachsemester #2 20/10/2010 Vladimir Dyakonov [email protected] VL-Folien: http://www.physik.uni-wuerzburg.de/ep6/vorlesung- WS1011/index.html Inhalt der Vorlesung
Physik für Mediziner im 1. Fachsemester #2 20/10/2010 Vladimir Dyakonov [email protected] VL-Folien: http://www.physik.uni-wuerzburg.de/ep6/vorlesung- WS1011/index.html Inhalt der Vorlesung
Versuch 8 Konzentrations- und Temperaturabhängigkeit der Zersetzungsspannung
Modultitel Studiengang Versuch 8 Konzentrations- und Temperaturabhängigkeit der Zersetzungsspannung Versuchsdurchführung am Betreuer: Gruppe Namen 1. Ziel des Versuches In diesem Versuch sollen die Temperatur-
Modultitel Studiengang Versuch 8 Konzentrations- und Temperaturabhängigkeit der Zersetzungsspannung Versuchsdurchführung am Betreuer: Gruppe Namen 1. Ziel des Versuches In diesem Versuch sollen die Temperatur-
LN Vortermin SS 02. PC Teil
 LN Vortermin SS 02 PC Teil 1. 15g Magnesium werden mit Salzsäure im Überschuß versetzt. Folgende Standardbildungsenthalpien bei 198K sind dazu gegeben: Mg 2+ -466,85 kj/mol Cl - aq -167,16 kj/mol a) Berechnen
LN Vortermin SS 02 PC Teil 1. 15g Magnesium werden mit Salzsäure im Überschuß versetzt. Folgende Standardbildungsenthalpien bei 198K sind dazu gegeben: Mg 2+ -466,85 kj/mol Cl - aq -167,16 kj/mol a) Berechnen
B Chemisch Wissenwertes. Arrhénius gab 1887 Definitionen für Säuren und Laugen an, die seither öfter erneuert wurden.
 -I B.1- B C H E M I S C H W ISSENWERTES 1 Säuren, Laugen und Salze 1.1 Definitionen von Arrhénius Arrhénius gab 1887 Definitionen für Säuren und Laugen an, die seither öfter erneuert wurden. Eine Säure
-I B.1- B C H E M I S C H W ISSENWERTES 1 Säuren, Laugen und Salze 1.1 Definitionen von Arrhénius Arrhénius gab 1887 Definitionen für Säuren und Laugen an, die seither öfter erneuert wurden. Eine Säure
Dynamik der Ammoniaksynthese
 Dynamik der Ammoniaksynthese Peter Bützer Die intellektuelle Verantwortlichkeit besteht darin, eine Sache so klar und deutlich hinzustellen, dass man dem Betreffenden, wenn er etwas Falsches oder Unklares
Dynamik der Ammoniaksynthese Peter Bützer Die intellektuelle Verantwortlichkeit besteht darin, eine Sache so klar und deutlich hinzustellen, dass man dem Betreffenden, wenn er etwas Falsches oder Unklares
Einführung in die Physikalische Chemie: Inhalt. Einführung in die Physikalische Chemie:
 Einführung in die Physikalische Chemie: Inhalt Einführung in die Physikalische Chemie: Inhalt Kapitel 9: Prinzipien der Thermodynamik Inhalt: 9.1 Einführung und Definitionen 9.2 Der 0. Hauptsatz und seine
Einführung in die Physikalische Chemie: Inhalt Einführung in die Physikalische Chemie: Inhalt Kapitel 9: Prinzipien der Thermodynamik Inhalt: 9.1 Einführung und Definitionen 9.2 Der 0. Hauptsatz und seine
5. Reaktionsgleichungen und Stoffmenge
 - 40-5. Reaktionsgleichungen und Stoffmenge Reaktionsgleichungen Reaktionsgleichungen dienen zur qualitativen und quantitativen Beschreibung chemischer Reaktionen. Qualitative Aussage: Welche Edukte werden
- 40-5. Reaktionsgleichungen und Stoffmenge Reaktionsgleichungen Reaktionsgleichungen dienen zur qualitativen und quantitativen Beschreibung chemischer Reaktionen. Qualitative Aussage: Welche Edukte werden
Elektrolyte. (aus: Goldenberg, SOL)
 Elektrolyte Elektrolyte leiten in wässriger Lösung Strom. Zu den Elektrolyten zählen Säuren, Basen und Salze, denn diese alle liegen in wässriger Lösung zumindest teilweise in Ionenform vor. Das Ostwaldsche
Elektrolyte Elektrolyte leiten in wässriger Lösung Strom. Zu den Elektrolyten zählen Säuren, Basen und Salze, denn diese alle liegen in wässriger Lösung zumindest teilweise in Ionenform vor. Das Ostwaldsche
Fachbereich Ökotrophologie Prof. Häusler SoSe 2005 Biochemie Definition und Fachgebiete
 Biochemie Definition und Fachgebiete Grenzwissenschaft zwischen Chemie, Biologie, Agrarwissenschaften und Medizin Spezialgebiete wie Immunchemie, Neurochemie, Pathobiologie, Genetik, Molekularbiologie,
Biochemie Definition und Fachgebiete Grenzwissenschaft zwischen Chemie, Biologie, Agrarwissenschaften und Medizin Spezialgebiete wie Immunchemie, Neurochemie, Pathobiologie, Genetik, Molekularbiologie,
Allgemeine Chemie für Studierende mit Nebenfach Chemie Andreas Rammo
 Allgemeine Chemie für Studierende mit Nebenfach Chemie Andreas Rammo Allgemeine und Anorganische Chemie Universität des Saarlandes E-Mail: [email protected] innere Energie U Energieumsatz bei
Allgemeine Chemie für Studierende mit Nebenfach Chemie Andreas Rammo Allgemeine und Anorganische Chemie Universität des Saarlandes E-Mail: [email protected] innere Energie U Energieumsatz bei
Ch 9.2 Stoffe, Experimente: ein erster Blick in die Chemie
 Katalog Apps für 9 II/III (und auch 8I) Ch 9.2 Stoffe, Experimente: ein erster Blick in die Chemie Allgemeines: Laborgeräte 1. Chemische Laborgeräte: Paare zuordnen 2. Memory Laborgeräte 3. Laborgeräte
Katalog Apps für 9 II/III (und auch 8I) Ch 9.2 Stoffe, Experimente: ein erster Blick in die Chemie Allgemeines: Laborgeräte 1. Chemische Laborgeräte: Paare zuordnen 2. Memory Laborgeräte 3. Laborgeräte
1 Lambert-Beersches Gesetz
 Physikalische Chemie II Lösung 6 23. Oktober 205 Lambert-Beersches Gesetz Anhand des idealen Gasgesetzes lässt sich die Teilchenkonzentration C wie folgt ausrechnen: C = N V = n N A V pv =nrt = N A p R
Physikalische Chemie II Lösung 6 23. Oktober 205 Lambert-Beersches Gesetz Anhand des idealen Gasgesetzes lässt sich die Teilchenkonzentration C wie folgt ausrechnen: C = N V = n N A V pv =nrt = N A p R
 www.zaubervorlesung.de Institut für Anorganische Chemie Institut für Anorganische Chemie Universität Erlangen-Nürnberg Donnerstag 19. Okt. 2006 Einlass: 18:00 Uhr Beginn: 20:00 Uhr Getränke dürfen nur
www.zaubervorlesung.de Institut für Anorganische Chemie Institut für Anorganische Chemie Universität Erlangen-Nürnberg Donnerstag 19. Okt. 2006 Einlass: 18:00 Uhr Beginn: 20:00 Uhr Getränke dürfen nur
Chem. Grundlagen. ure-base Begriff. Das Protonen-Donator-Akzeptor-Konzept. Wasserstoff, Proton und Säure-Basen. Basen-Definition nach Brønsted
 Der SäureS ure-base Begriff Chem. Grundlagen Das Protonen-Donator-Akzeptor-Konzept Wasserstoff, Proton und Säure-Basen Basen-Definition nach Brønsted Wasserstoff (H 2 ) Proton H + Anion (-) H + = Säure
Der SäureS ure-base Begriff Chem. Grundlagen Das Protonen-Donator-Akzeptor-Konzept Wasserstoff, Proton und Säure-Basen Basen-Definition nach Brønsted Wasserstoff (H 2 ) Proton H + Anion (-) H + = Säure
